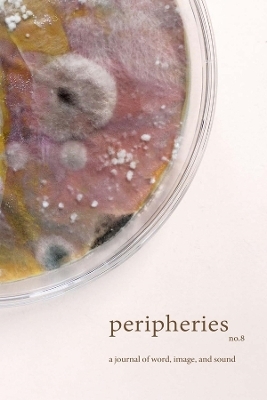
Peripheries: A Journal of Word, Image, and Sound, No. 8 -

Peripheries: A Journal of Word, Image, and Sound, No. 8
Seiten
2026
Harvard University Press (Verlag)
978-0-674-30509-0 (ISBN)
Harvard University Press (Verlag)
978-0-674-30509-0 (ISBN)
- Noch nicht erschienen (ca. Mai 2026)
- Portofrei ab CHF 40
- Auch auf Rechnung
- Artikel merken
| Erscheint lt. Verlag | 12.5.2026 |
|---|---|
| Verlagsort | Cambridge, Mass |
| Sprache | englisch |
| Themenwelt | Literatur ► Lyrik / Dramatik ► Lyrik / Gedichte |
| Kunst / Musik / Theater ► Musik | |
| ISBN-10 | 0-674-30509-4 / 0674305094 |
| ISBN-13 | 978-0-674-30509-0 / 9780674305090 |
| Zustand | Neuware |
| Informationen gemäß Produktsicherheitsverordnung (GPSR) | |
| Haben Sie eine Frage zum Produkt? |
Mehr entdecken
aus dem Bereich
aus dem Bereich
Kurzgeschichten für die Seele – zum Entspannen und Nachdenken
Buch | Softcover (2025)
Lehmanns Media (Verlag)
CHF 19,90


